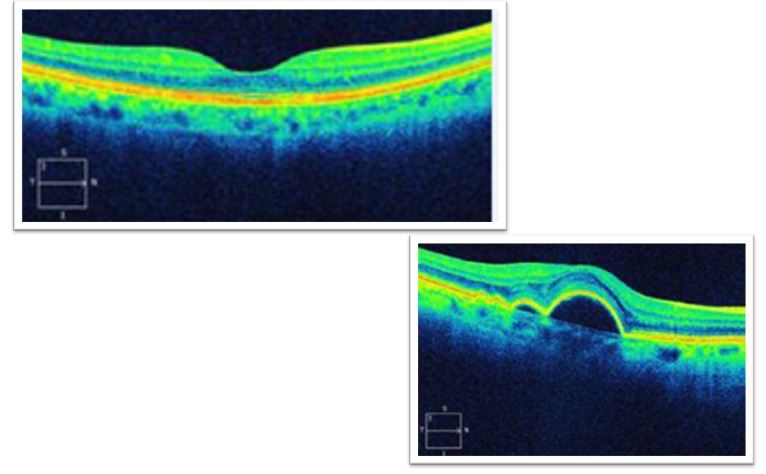

Retina
The retina is a direct extension of the CNS. It consists of a neural and non-neural portions:
- The neural portion contains photoreceptors and other cells (bipolar and ganglion cells) which conduct signals from the photoreceptors to the optic nerve.
- The non-neural portion is the retinal pigment epithelium
Photoreceptors
- Light needs to be converted into nerve impulses and the cells that can do this are the photoreceptors
- We have 180 million photoreceptors and there are 2 types: rods and cones
- Rods are much more numerous (>110mill) than cones (6.3-6.8 million)
- Not uniformly distributed across the retin
Distribution of rods and cones

Rods and cones
- Inner segment - cell nucleus
- Outer segment - light absorbing pigments in stacked discs
- Pigment molecule in each disc are comprised of small light absorbing molecules (retinal) attached to large protein (opsin)
- There are approx 100 million pigment molecules per photoreceptor

Photoreceptors
- The retinal molecule in the photo-pigment is a derivative of Vitamin A
- Retinal can assume different isometric conformations
- In its non-activated state retinal attaches snugly on to its binding site on the opsin-molecule
- The visual pigment (retinal and opsin) contained in rods is called Rhodopsin
- There are 3 types of cone, each with a different type of opsin which interacts distinctly with the retinal. These are the foundation of our trichromatic colour vision
- When light is absorbed by rhodopsin, retinal changes its configuration and no longer fits in the opsin binding site
- This causes the retinal to detach from the opsin
- This begins a cascade of chemical events
- This results in a change of the electrical state of the cell membranes (hyperpolarisation) and consequently the release of neurotransmitters
- Light energy is changed into electrical energy
Properties of rods
Rods are very sensitive to light
- They contain more photopigment than cones and can capture more light
- A single photon of light can activate rhodopsin which effectively amplifies the signal from dim light
- Signals from many rods converge onto the next retinal cell in the neural chain, pooling or strengthening the rod signals
- This means that rods help us see in dim light but their ability to see fine detail is poor
Properties of cones
- Cones function best in moderate to bright light
- must absorb 100s of photons for their photopigment to be activated
- Cones are responsible for our ability to see fine details and high level visual acuity
- Unlike rods, only a few cones converge on the next retinal cell
- At the fovea they synapse onto only one relay retinal cell
- Cones also respond to different wavelengths of light
Rods v Cones
- While rods have one photopigment (rhodopsin), cones have 3 photopsins
- In bright light when the cones pigments are being activated, the rods are inactive
Conversely - In dim light, cones are not activated
- This means that our peripheral vision in bright light is mediated by the sparse cones in the periphery of our retina
Comparison Of Photoreceptors

Cells other than photoreceptors
Cells that transmit the information from the photoreceptors to the optic nerve are:
- Bipolar cells, ganglion cells.
Interneurons that modulate transmission between photoreceptors and bipolar cells and between bipolar cells and ganglion cells are:
- Horizontal cells
- Amacrine cells
Typical neuron consists of:
- Cell body (soma) containing the cell’s nucleus
- Dendrites - connected to other cells
- An axon - which converys neuronal impulses over variable distances
- Terminal branches - which end in synapses connecting to the next neuron
Layers of the retina
The photoreceptive cells lie deepest within the retina and interdigitate with the pigment epithelium.
Light entering the eye passes through, and is refracted and partially absorbed by these additional elements before reaching the photoreceptors. This stops the scattering of light and enables us to see. A very important design feature of the retina. The fovea differs in design to enable the fine detailed viewing.
Light is stopped by the pigment epithelium. Information then travels forward from the photoreceptor layer to the nerve fibre layer.

Pigment epithelium and membranes
The dark retinal pigment epithelium (RPE):
- lies behind the photoreceptors
- contains melanin
- has an important function in preventing scattering of light within the retina
- and in phagocytosis of photoreceptor pigments
The membranes of the retina:
- appear to have only a structural function
- have holes - externally for processes of the photoreceptors, internally for blood vessels
- but not at the fovea
Retinal nuclear (cell body) zones

Layers containing photoreceptor components
Photoreceptors are present in the photoreceptor layer (2) & outer nuclear layer (4).
The photoreceptor layer contains the outer segment & part of the inner segment of the cell.
The outer nuclear layer contains the cell bodies of photoreceptos.
The inner nuclear layer contains:
Bipolar cells - directly link cones to retinal ganglion cells, indirectly links rods via amacrine cells
Amacrine cells - link to bipolar cells
Horizontal cells - modulate photoreceptor input to bipolar cells
Plexiform retinal layers
- Plexiform (molecular) layers contain the terminal branches of neural cells making connections with dendrites of other cellls
- Outer plexiform layer
- photoreceptor branches connecting with dendrites of bipolar cells and horizontal cells
- Inner plexiform layer
- Branches of the bipolar and some amacrine cells connecting with the retinal ganglion cell (RGC) dendrites
Macula region (macula lutea)
The macula is the area of the reina which is specifically modified for maximal resolving power/ visual acuity.
Inline with the visual axis, is the fovea centralis. It is about 1.5mm in diameter (the floor of the depression is the foveola). This depressed area is formedby the neurons and capillaries of the inner layers of the retina being displaced peripherally (therefore only cones are at the very centre) this enables incoming light to have greater access to the photoreceptors.
Foveola = total 1.2o = cones only
Fovea centralis = total 5o (when discussing the fovea)
Parafovea = total 8.4o
Perifovea = 18.40

Layers at the fovea
The adult fovea:
- No ganglion cell layer or inner nuclear layer (no bipolar cell bodies)
- RPE
- Outer and inner segments of photoreceptors
- outer nuclear layer (photoreceptor cell bodies)
- FH (fibres of Henle) - stretched out axons of the photoreceptors going to the displaced bipolar cells

Fovea

Fovea using Optical Coherence Tomography
The nerve fibre layer
- Retinal Ganglion cells (RGCs) axons travel in the top layer of the retina
- The layer closest to the vitreous
- They form bundles which travel towards the optic nerve head (ONH) to exit the eye

Optic nerve
- The RGC fibres travel in bundles and exit the eye in an order related to the topography of the retina
- The axons within the ON tend to retain this topographical order
- The lamina cribrosa generally marks the point at which the RGC axons become myelinated
Topography in the optic nerve/tract
- Behind the eye, macular fibres occupy 1/3rd of the ON & are located temporally
- Approaching the chiasm macular fibres movetowards the centre
- In the OT macular fibres are upper-most (dorsal), peripheral fibres below
- These then terminate in the LGN - now part of the cerebral cortex



